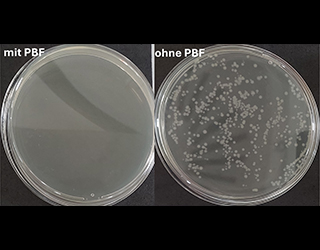

Plasmabehandelte Flüssigkeiten haben das Potential, den Einsatz herkömmlicher Reinigungs- und Desinfektionsmittel zu reduzieren. Am Fraunhofer FEP werden die Zusammenhänge der reinigenden und hygienisierenden Wirkung, sowie der Lagerfähigkeit erforscht.
Plasmaaktiviertes Wasser (PAW), auch mit dem Oberbegriff plasmabehandelte Flüssigkeit (PBF) bezeichnet, ist für seine desinfizierende Wirkung bekannt. Plasmabehandelte Flüssigkeiten werden durch die Einleitung des ionisierten Gases von Atmosphärendruck-Plasmaquellen in Flüssigkeiten hergestellt, wodurch sich die durch die Plasmaquelle erzeugten reaktiven Stickstoff- und Sauerstoffspezies in der Flüssigkeit lösen bzw. mit Flüssigkeitsbestandteilen reagieren. Aufgrund der Vielzahl unterschiedlicher reaktiver Spezies sowie des damit einhergehenden niedrigen pH-Werts und hohen Redox-Potentials zeigen diese Flüssigkeiten eine mikrobizide Wirkung. Aufgrund der hohen Reaktivität besteht zudem das Potential zum Einsatz als Reinigungsmittel. Im Rahmen unserer Forschungstätigkeit zu PBF untersuchen wir die hygienisierende, aber auch die reinigende Wirkung sowie die Eignung zum kombinierten Einsatz für Reinigung und Desinfektion. Grundlegend werden für die Fragestellungen Zusammenhänge zur Wirksamkeit und zum Effekt der verschiedenen reaktiven Spezies untersucht, um basierend auf diesen Resultaten die Herstellungstechnologie zu optimieren und den industriellen Einsatz von PBF wirtschaftlich attraktiv und reproduzierbar zu gestalten.
In unseren Untersuchungen werden verschiedene Modell-Mikroorganismen betrachtet, um die hygienisierende Wirkung von PBF unter variierenden Herstellungs- und Umgebungsbedingungen zu bewerten. Beispielsweise konnte bereits bei einer kurzen Behandlungszeit von nur 5 Minuten an Verunreinigungen aus Escherichia coli eine Reduktion um 99,99 % erzielt werden (siehe Abbildung). Zur Untersuchung der Reinigungsleistung kann beispielsweise die schonende Entfernung von Graphitresten auf porösen Quarzoberflächen angeführt werden.
Neben der reinigenden und hygienisierenden Wirkung stellt die Lagerfähigkeit der PBF einen wichtigen Punkt für den industriellen Einsatz dar. Diesbezüglich konnten wir in ersten Untersuchungen zeigen, dass die Flüssigkeiten über 10 Monate ihre Reaktivität behalten.
Im Fokus weiterer Forschungsarbeit stehen die Zusammenhänge zwischen Plasmaquelle und Eigenschaften bzw. Spezies-Gehalt der erzeugten PBF sowie geeignete Monitoringmethoden zur reproduzierbaren industriellen Implementierung.
 Fraunhofer-Institut für Elektronenstrahl-
Fraunhofer-Institut für Elektronenstrahl-